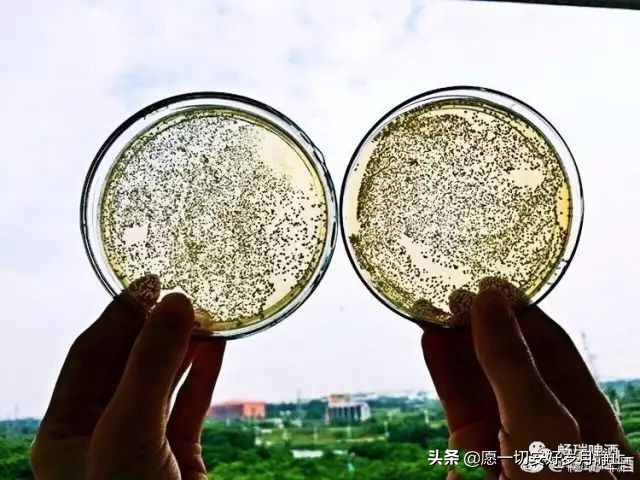
原浆啤酒和普通啤酒区别在哪,啤酒原浆跟普通的啤酒有什么区别

什么是原浆啤酒:不加水,不经过滤,不经灭活工序,保留鲜活酵母的生啤酒原液,高浓度的经过发酵的大麦汁,称之为原浆啤酒!

定 义
与其他普通啤酒最大的区别是100%麦芽发酵,原浆啤酒未经过滤处理保留了发酵过程中的活性酵母。因含有一定量的活性酵母呈现一定浊度,酒体泡沫极其丰富,香气浓郁,口味新鲜纯正,风味独特,是啤酒家族中名符其实的超级液体面包。
原浆啤酒因为未经过过滤!必定的会产生一些营养成分的沉淀!色泽上呈现浑浊现象属于正常!
原浆啤酒就是没有经过高温或低温处理、后期修饰的啤酒发酵原液。是最新鲜、最原始的真正的啤酒。(或者说其实就是啤酒厂刚生产出来不经过任何处理的原汁原味的啤酒)
喝普通啤酒就象吃“苹果罐头” ,而喝原浆啤酒就如在苹果园里摘新鲜的苹果吃。

制造过程
原浆啤酒是全程无菌状态下酿造出来的啤酒发酵原液,最大限度地保留了活性物质和营养成分,是高档而最新鲜的啤酒,完全保留了发酵过程中产生的氨基酸、蛋白质以及大量的钾、镁、钙、锌等微量元素,其中最关键的就是保留了大量的活性酵母,能有效地提高人体的消化和吸收功能,同时也保持了啤酒最原始、最新鲜的口感,麦香浓郁,色泽金黄,泡沫极其丰富,如牛奶般洁白、细腻,持久挂杯,真正啤酒中的高端产品,是现有啤酒根本无法比拟的。
原浆啤酒是直接从发酵罐中分装的嫩啤酒原液。与其他啤酒相比,原浆啤酒在酿造过程中未过滤,不经高温巴氏灭活工序,呈朦胧状原浆的新鲜美味及丰富营养亦被完全的保存下来;低温灌装和贮存(0~5℃),瞬时锁定第一时间的新鲜度,口味鲜美无双,地道纯正。
营 养
原浆啤酒中的酵母优质鲜活,富含人体必需的氨基酸、维生素和矿物质,其中氨基酸的含量特别丰富,氨基酸的配比接近联合国粮农组织(FAO)推荐比例,并且其酵母蛋白的营养价值接近动物蛋白,可以有效改善人类的营养比例。
